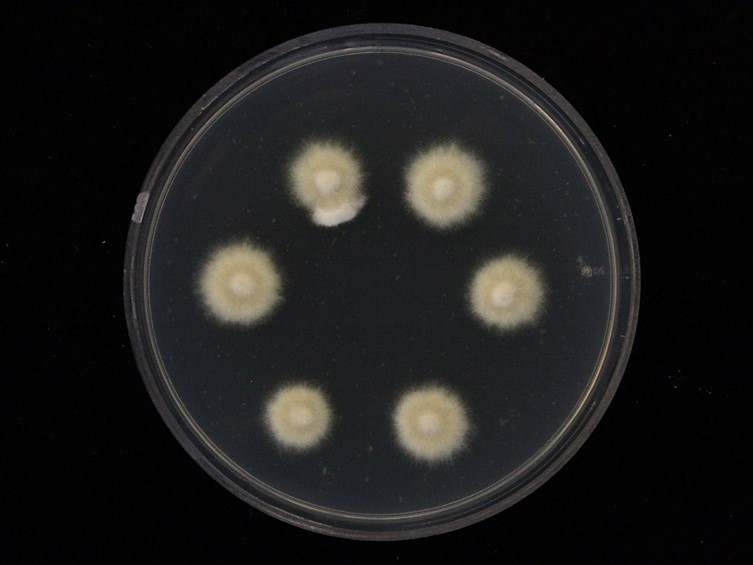

Holotype:
THAILAND, Nakhon Ratchasima Province, Khao Yai National Park, 10 February 2010, K. Tasanathai, P. Srikitikulchai, S. Mongkolsamrit, T. Chohmee, R. Ridkaew, A. Khonsanit, holotype BBH 28509, ex-type living culture BCC 41203.
Habitat:
Underside of a dicotyledonous leaf.
Host:
On Storenomorpha sp.
Description:
 Spider host completely covered by white to yellowish-white mycelial mat.
Spider host completely covered by white to yellowish-white mycelial mat.  Synnemata solitary or in pairs, cylindrical, white, becoming yellowishwhite at the base.
Synnemata solitary or in pairs, cylindrical, white, becoming yellowishwhite at the base.  Conidiophores arising along the entire length of the outer hyphae of synnemata and from the mycelia covering the host, crowded, smooth to verrucose, 55–226 × 5–12.5 µm, narrowing to a slender apex, and terminating in a swollen vesicle, metulae, phialides bearing
Conidiophores arising along the entire length of the outer hyphae of synnemata and from the mycelia covering the host, crowded, smooth to verrucose, 55–226 × 5–12.5 µm, narrowing to a slender apex, and terminating in a swollen vesicle, metulae, phialides bearing  conidia, forming a spherical conidial head.
conidia, forming a spherical conidial head.  Conidial heads 25–45 µm diam. Vesicles mostly globose, 4.5–10 µm diam. Metulae borne on a vesicle, broadly obovoid, 5.5–10 × 3–7.5 µm, bearing phialides. Phialides obovoid to clavate, with a distinct short neck, 5–9 × 2–4.5 µm. Conidia produced on a phialide, obovoid with an acute apex, 2.5–5.5 × 1–3 µm.
Conidial heads 25–45 µm diam. Vesicles mostly globose, 4.5–10 µm diam. Metulae borne on a vesicle, broadly obovoid, 5.5–10 × 3–7.5 µm, bearing phialides. Phialides obovoid to clavate, with a distinct short neck, 5–9 × 2–4.5 µm. Conidia produced on a phialide, obovoid with an acute apex, 2.5–5.5 × 1–3 µm.  Perithecia produced on the mycelial mat on the head and body of the spider, scattered, superficial with loose mycelia covering only the bottom one-fourth of the perithecium, ovoid, reddish-yellow, 790–1,150 × 300–475 µm.
Perithecia produced on the mycelial mat on the head and body of the spider, scattered, superficial with loose mycelia covering only the bottom one-fourth of the perithecium, ovoid, reddish-yellow, 790–1,150 × 300–475 µm.  Asci cylindrical, 700–750 µm long, 4.5–7 µm wide, ascus cap 4–7 × 3.5–5.5 µm.
Asci cylindrical, 700–750 µm long, 4.5–7 µm wide, ascus cap 4–7 × 3.5–5.5 µm.  Ascospores filiform, multiseptate, arranged in parallel rows, 666–730 × 2–3 µm, often breaking into 128 part-spores. Part-spores bacilliform with apices rounded, 3.5–9 × 1–3 µm.
Ascospores filiform, multiseptate, arranged in parallel rows, 666–730 × 2–3 µm, often breaking into 128 part-spores. Part-spores bacilliform with apices rounded, 3.5–9 × 1–3 µm.  Granulomanus-like asexual morph occasionally present, forming irregularly branched hyphae bearing mono- or polyblastic phialides. Phialides irregularly in shape, mostly smooth, with one or more conspicuous denticles. A conidium borne on each denticle, long, filiform, 16–22.5 × 1–1.5 µm.
Granulomanus-like asexual morph occasionally present, forming irregularly branched hyphae bearing mono- or polyblastic phialides. Phialides irregularly in shape, mostly smooth, with one or more conspicuous denticles. A conidium borne on each denticle, long, filiform, 16–22.5 × 1–1.5 µm.
Culture characteristics:
Colonies on PDA slow-growing, attaining a diam of 1.5±0.2 cm in 4 weeks at 25 °C, white, floccose; reverse light brown, darkening with age toward center.
Colonies on PDA slow-growing, attaining a diam of 1.5±0.2 cm in 4 weeks at 25 °C, white, floccose; reverse light brown, darkening with age toward center.
Other Available strains
TBRC-BCC 37860 , TBRC-BCC 38246 , TBRC-BCC 39007 , TBRC-BCC 39707 , TBRC-BCC 39709Reference:
Kuephadungphan W, Tasanathai K, Petcharad B, et al. (2020). Phylogeny- and morphology-based recognition of new species in the spider-parasitic genus Gibellula (Hypocreales, Cordycipitaceae) from Thailand. MycoKeys72: 17–42.
DOI: https://doi.org/10.3897/mycokeys.72.55088Species |
Strain |
Compound |
Pubchem CID |
Biological activity |
Reference |
|---|---|---|---|---|---|
| Gibellula pigmentosinum | TBRC-BCC 37860 | Pigmentosin A (1) | 159931 | Antimicrobial acitvity against S. aureus; Antimicrobial acitvity against E. coli | Helaly et al. 2019 |
| Gibellula pigmentosinum | TBRC-BCC 38246 | Pigmentosin B (2) | 159931 | Antimicrobial acitvity against S. aureus; Antimicrobial acitvity against E. coli | Helaly et al. 2019 |
|
Strain |
ITS | LSU | RPB1 | RPB2 | TEF1 |
|---|---|---|---|---|---|
| BCC 38246 | MH532872 | MH394672 | - | MH521855 | MH521893 |
| BCC 39707 | MH532875 | MH394674 | MH521801 | MH521856 | MH521894 |
| BCC 41203 | MT477071 | - | - | - | MT503330 |
| BCC 41870 | MT477072 | MT477064 | MT503324 | - | MT503331 |